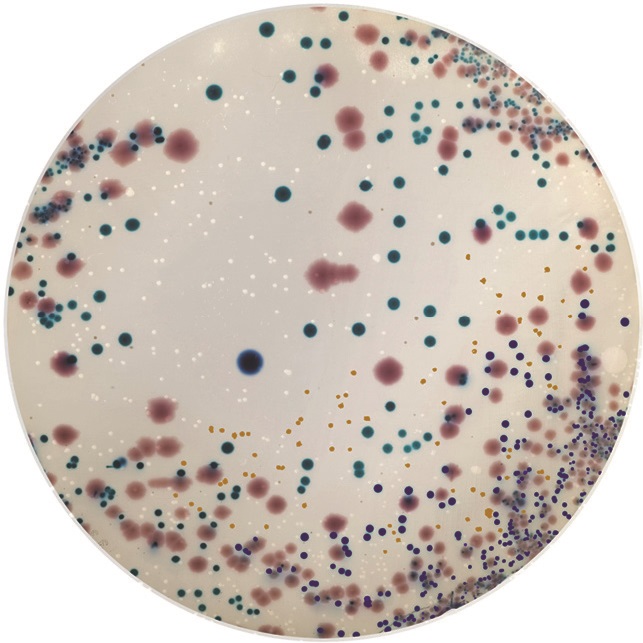

导航
导航
西班牙康达Condalab 尿路感染显色培养基(UTIC)
![]() |
Urinary Tract Infections Chromogenic Agar (UTIC) 品牌:西班牙康达Condalab 货号:1424 规格:47.5g/L 应用:用于检测和鉴别引起尿路感染的微生物。 应用领域:临床 |
组分 g/L:琼脂和蛋白胨混合物16g/L; 生长因子13g/L; 色氨酸2g/L; 显色混合物0.5g/L
PH值:7.2±0.2
操作步骤:
1、取瓶内干粉47.5g,溶于1000ml去离子水的洁净三角瓶中。
2、缓慢加热,不停搅拌,使其完全溶解。
3、将溶解完全的培养基高压灭菌(121ºC,15min)。
4、加热后的培养基冷却至45-50ºC,轻轻地摇动均匀,倾注平皿,使其凝固,晾干备用。
保存:该成品平板在室温可保存一天或在冰箱内储存2周(2-8ºC,避光)。
接种:划线或涂布接种(冰箱内保存的平板使用前应恢复至室温)。
培养:(35±2 ºC/18-24 h, 48-72h菌落最佳)
结果:
|
微生物(Microorganisms) |
生长情况 |
特征反应 |
|
产气肠杆菌 ATCC®13048 |
生长良好 |
深蓝色 |
|
肺炎克雷伯菌ATCC®13883 |
生长良好 |
深蓝色 |
|
鼠伤寒沙门氏ATCC®14028 |
生长良好 |
琥珀色(黄色) |
|
铜绿假单胞菌ATCC®27853 |
生长良好 |
琥珀色(黄色) |
|
伤寒沙门氏菌 ATCC®6539 |
生长良好 |
琥珀色(黄色) |
|
粪肠球菌 ATCC®19433 |
生长良好 |
浅蓝色 |
|
奇异变形杆菌ATCC®25933 |
生长良好 |
浅棕色 |
|
大肠杆菌 ATCC®25922 |
生长良好 |
粉红色 |
|
金黄色葡萄球ATCC®25923 |
生长良好 |
(色素沉着)白色奶油状菌落 |
应用:对于临床诊断,样本类型为尿液,用拭子涂布接种,在35±2°C的有氧条件下培养18-24小时后读取结果。
污染处理:使用过的培养基需要在121ºC灭菌至少20分钟才可以按照有关规定丢弃。
附:供体外诊断使用,产品需专业人员操作。
亚洲精品无码成人A片色欲-性视频播放免费视频-这里是国产精品视频一区二区-久久精品人妻av-国产丰满老熟妇乱XXX
公司地址:河南省濮阳县铁丘路路南中稹绿探院内3号楼
联系电话:13137349799
E-mail:[email protected]
性视频播放免费视频
公司地址:河南省濮阳县铁丘路路南中稹绿探院内3号楼
联系电话:17310820029
E-mail:[email protected]
© 2021 亚洲精品无码成人A片色欲-性视频播放免费视频-这里是国产精品视频一区二区-久久精品人妻av-国产丰满老熟妇乱XXX ALL Rights Reserved 备案号:豫ICP备2023018085号 技术支持:新网